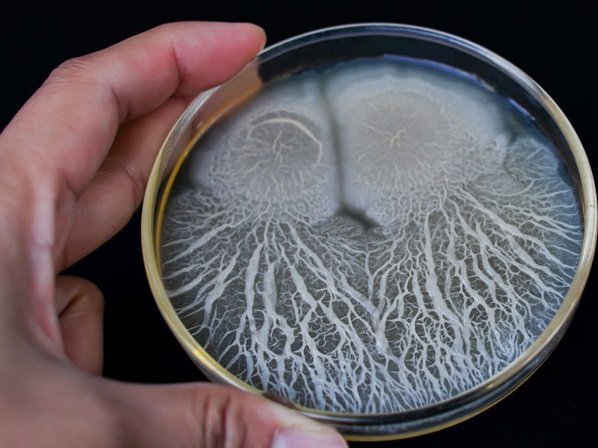

Các nhà nghiên cứu sử dụng bào tử vi khuẩn mã hóa DNA để cải thiện khả năng truy xuất nguồn gốc thực phẩm
TNNN - Nhóm nghiên cứu đã mô tả bằng cách nào các bào tử vi khuẩn tổng hợp có thể được đưa vào các vật thể và bề mặt một cách an toàn tại một điểm xuất phát, chẳng hạn như một cánh đồng hoặc nhà máy sản xuất, và được phát hiện và xác định nhiều tháng sau đó, do đó cải thiện khả năng truy xuất nguồn gốc.
- Phương pháp cân trong phòng thử nghiệm: Cân chuyển toàn lượng (phần 3)
- Thử nghiệm lâm sàng thuốc Covid-19 từ huyết tương bò
Với sự phức tạp ngày càng tăng của nguồn cung thực phẩm toàn cầu, các nhà khoa học của Trường Y Harvard (HMS) đã phát triển một hệ thống vi khuẩn mã hóa DNA có thể được sử dụng để dán nhãn các vật thể nông nghiệp theo cách thức rẻ tiền, có thể mở rộng và đáng tin cậy.
Các bào tử có nguồn gốc từ men của thợ làm bánh và một chủng vi khuẩn phổ biến được sử dụng trong nhiều ứng dụng khác nhau, chẳng hạn như bổ sung chế độ ăn uống sinh học, và được thiết kế để không có khả năng phát triển trong tự nhiên để ngăn ngừa các tác động sinh thái bất lợi.
“Các bào tử là một giải pháp truyền thống và được phun một cách an toàn vào hàng hóa nông nghiệp dưới dạng chế phẩm đất hoặc thuốc trừ sâu sinh học trong nhiều thập kỷ. Chúng tôi vừa thêm một chuỗi DNA nhỏ mà chúng tôi có thể khuếch đại và phát hiện", chuyên gia nghiên cứu tương ứng Michael Springer, phó giáo sư sinh học hệ thống cảu Viện Blavatnik tại HMS cho biết.
“Chúng tôi cũng đã làm việc chăm chỉ để đảm bảo hệ thống này an toàn, sử dụng các chủng vi khuẩn phổ biến và xây dựng ở nhiều cấp độ kiểm soát”, Spring Springer cho biết thêm. “Chúng tôi hy vọng nó có thể được sử dụng để giúp giải quyết các vấn đề có ý nghĩa kinh tế và sức khỏe cộng đồng rất lớn”.
Theo các nhà nghiên cứu, việc sử dụng các chuỗi DNA được tổng hợp tùy chỉnh như mã vạch đã được chứng minh trên nguyên tắc là có hiệu quả để dán nhãn thực phẩm và các mặt hàng khác. Để được sử dụng rộng rãi, mã vạch DNA phải được sản xuất với giá rẻ và với khối lượng lớn, tồn tại trên các vật thể trong môi trường biến đổi cao và có thể được giải mã nhanh chóng và đáng tin cậy - những rào cản cho đến nay vẫn chưa được khắc phục vì DNA rất dễ vỡ, họ giải thích.
Trong nghiên cứu của họ, Springer và các đồng nghiệp đã xác định xem liệu mã vạch DNA được đóng gói trong các bào tử vi khuẩn, có thể được phun lên cây trồng và được xác định nhiều tháng sau đó, có thể giúp giải quyết những thách thức này hay không.
Nhóm nghiên cứu đã tạo ra các chuỗi DNA tùy chỉnh mà họ tích hợp vào bộ gen của các bào tử của hai loại vi sinh vật - Saccharomyces cerevisiae và Bacillus subtilis.
Được đưa vào bộ gen song song, các chuỗi được thiết kế sao cho hàng tỷ mã vạch độc đáo có thể được tạo ra.
Nhóm nghiên cứu đảm bảo rằng các bào tử mã hóa DNA không thể nhân lên, phát triển và lan truyền trong tự nhiên bằng cách sử dụng các chủng vi sinh vật cần bổ sung dinh dưỡng cụ thể và bằng cách xóa các gen cần thiết cho bào tử nảy mầm và phát triển.
“Các bào tử có thể tồn tại trong tự nhiên trong một thời gian rất dài và là phương tiện tuyệt vời để chúng ta kết hợp mã vạch DNA vào”, tác giả nghiên cứu đầu tiên Jason Qian, một sinh viên tốt nghiệp ngành sinh học hệ thống tại HMS cho biết. “Việc xác định mã vạch rất đơn giản, bằn cách sử dụng đầu đọc đĩa và bộ lọc nhựa màu cam trên máy ảnh điện thoại di động. Chúng tôi không hình dung bất kỳ thách thức nào cho khả năng triển khai tại hiện trường”.
Khi được phun lên cỏ bên ngoài và tiếp xúc với thời tiết tự nhiên trong vài tháng, các bào tử vẫn có thể phát hiện được, với sự lây lan tối thiểu bên ngoài khu vực bị nhiễm bệnh. Trên các môi trường như cát, đất, thảm và gỗ, các bào tử tồn tại trong nhiều tháng mà không bị mất theo thời gian và chúng được xác định sau các xáo trộn như hút bụi, quét và mô phỏng gió và mưa.
Đặc tính này, nhóm nghiên cứu lưu ý, có thể cho phép các bào tử được sử dụng để xác định xem một vật thể có đi qua khu vực bị nhiễm bệnh hay không. Họ đã kiểm tra điều này bằng cách chia hố cát thành các lưới điện, mỗi lưới được dán nhãn lên đến bốn bào tử mã vạch khác nhau. Các cá nhân và một chiếc xe điều khiển từ xa sau đó điều hướng hố cát.
Họ phát hiện ra rằng họ có thể xác định các lưới cụ thể mà các đối tượng đi qua với cực dương hoặc âm tính giả, cho thấy một ứng dụng có thể là một công cụ bổ trợ cho pháp lý hoặc thực thi pháp luật.
“Là những nhà khoa học, trách nhiệm của chúng tôi là giải quyết các thách thức khoa học, nhưng đồng thời chúng tôi muốn đảm bảo sự thừa nhận về ý nghĩa xã hội rộng lớn hơn”, ông Spring Springer nói. “Chúng tôi tin rằng các bào tử mã hóa phù hợp nhất cho các ứng dụng nông nghiệp và công nghiệp và sẽ không hiệu quả đối với sự giám sát của con người."
Các nhà nghiên cứu hiện đang tìm cách cải thiện hệ thống, bao gồm các cơ chế chuyển đổi tiêu diệt tiềm năng về kỹ thuật vào các bào tử, tìm cách hạn chế sự lan truyền và kiểm tra xem các bào tử có thể được sử dụng để cung cấp thông tin tạm thời về lịch sử vị trí.
“Sự bùng phát của các mầm bệnh gây hại thực phẩm như Listeria, Salmonella và E. coli xảy ra một cách tự nhiên và thường xuyên”, ông Spring Springer cho biết. “Các công cụ sinh học tổng hợp đơn giản, an toàn và kiến thức về sinh học cơ bản cho phép chúng ta tạo ra những thứ có nhiều tiềm năng trong việc giải quyết các vấn đề an toàn trong thế giới thực”.
Nguồn: https://www.mard.gov.vn/


Thiết kế pin mới giúp giảm nguy cơ cháy nổ

JASIS 2025 – Triển lãm thiết bị khoa học và phân tích hàng đầu châu Á

Cấp thiết sửa đổi quy chuẩn kỹ thuật quốc gia cho sản phẩm sữa chế biến

Kiểm tra, xác nhận giá trị sử dụng phương pháp; ước lượng độ không đảm bảo đo lĩnh vực sinh học

Đảm bảo chất lượng kết quả thử nghiệm

Nhận thức chung ISO/IEC 17025:2017 và đánh giá nội bộ

Xác nhận giá trị sử dụng phương pháp thử trong phân tích hóa học

Triệt để tránh tình trạng “dễ làm, khó bỏ” trong nghiên cứu khoa học

Báo động: Vi nhựa xâm nhập não người với tốc độ nhanh

Hiệu ứng nhà kính và các giải pháp từ tiêu chuẩn













